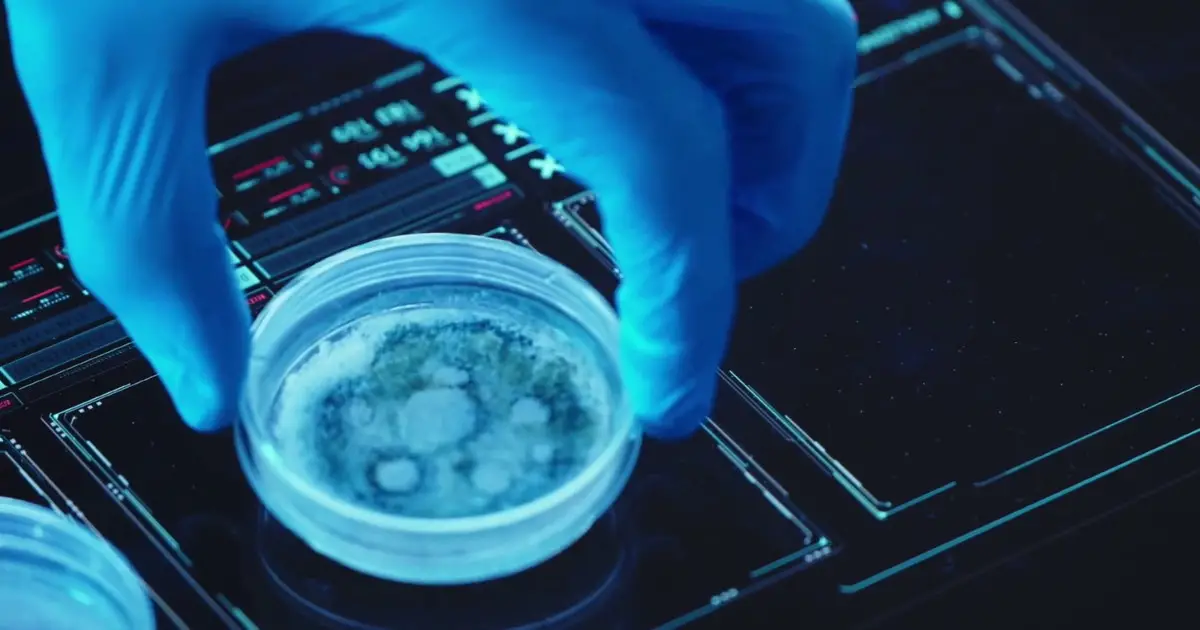
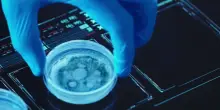

s
Malattie rare, la diagnosi adesso si fa con la tomografia olografica
10-10-2025, 16:15
Malattie rare, la diagnosi adesso si fa con la tomografia olografica
CONTINUA A LEGGERE

15

0

0
Guarda anche
Libero Quotidiano

Malattie rare, la diagnosi adesso si fa con la tomografia olografica
Il Tempo
Ieri, 23:48